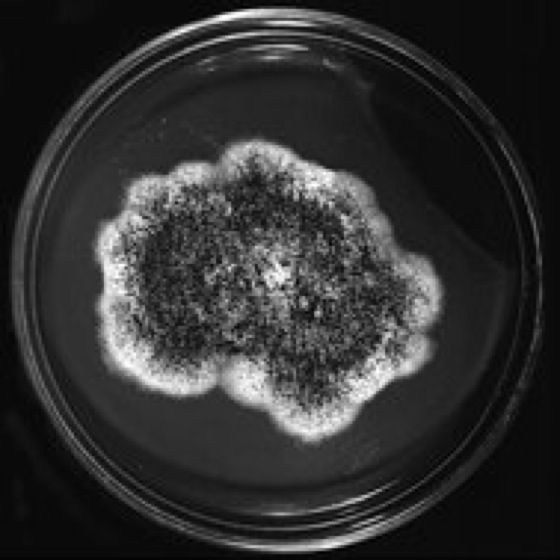

Lexikon der Biologie: Aspergillus
Aspergillus m [von latein. aspergillum = Wedel als Gerät zum Besprengen], Gießkannenschimmel, Kolbenschimmel, Pilze der Formgattung Moniliales. Aufgrund molekulargenetischer Untersuchungen werden viele Aspergillus-Arten, auch wenn noch keine sexuelle Fruchtform bekannt ist, als Gruppe mit Mitosporen-Bildung der Familie Trichocomaceae (Ordnung Eurotiales) zugeordnet. In der Biotechnologie und Phytopathologie ist Aspergillus die nicht korrekte, aber übliche Bezeichnung für Arten, deren NebenfruchtformenKonidien vom Aspergillus-Typ ausbilden, von denen aber bereits die Hauptfruchtform bekannt ist. Nach den Nomenklaturregeln müssen die Arten mit einer Hauptfruchtform eine gesonderte Gattungsbezeichnung erhalten: So sind die Vertreter der Aspergillus-glaucus-Gruppe die Nebenfruchtform von Eurotium-, die der Aspergillus-nidulans-Gruppe von Emericella- und die der Aspergillus-fumigatus-Gruppe von Neosartorya-(Sartorya-)Arten aus der Ordnung Eurotiales (Familie Trichocomaceae). Das Mycel der Aspergillus-Arten ist wattig-filzig, farblos bis lebhaft gefärbt, die Hyphen sind septiert. Die sehr vielen, kräftigen, manchmal mehrere Millimeter langen, typischen Konidienträger ( vgl. Abb. ) entstehen jeweils aus einer Hyphenzelle, der Fußzelle, die sich verzweigt und eine senkrechte Hyphe bildet. Die Konidien sind einzellig, meist kugelförmig mit stacheliger Oberfläche, und verleihen oft durch ihre Farbe (z. B. schwarz, grün, oliv, braun) der Kolonie ( vgl. Abb. ) ihre typische Färbung. Die zahlreichen Arten mit einer geschlechtlichen Vermehrungsphase bilden kugel- oder eiförmige, meist lebhaft gefärbte, feste Ascomata (Ascoma) aus; die zahlreichen Asci (Ascus) enthalten meist 8 Ascosporen. Die ca. 150 Aspergillus-Arten sind weltweit verbreitet, vor allem im Boden, und durch mannigfaltige Stoffwechselleistungen ausgezeichnet. Sie zersetzen pflanzliche und tierische Produkte und sind auch am Abbau von Cellulose und Chitin beteiligt. Die osmophile Aspergillus-glaucus-Gruppe (mit grünen Konidien) wächst auch auf Nahrungsmitteln mit höherer Salz- oder Zuckerkonzentration. Aspergillus-Mykotoxine in befallenem Futter können gefährliche bis tödliche Pilzvergiftungen (Mykotoxikosen) bei Haustieren hervorrufen. Aspergillus flavus und Aspergillus parasiticus bilden besonders auf fetthaltigen Früchten (Nüsse, Erdnüsse) die auch für den Menschen stark leberschädigenden und krebsauslösenden Aflatoxine. Das Mykotoxin Ochratoxin wird von Aspergillus ochraceus, Strigmatoxin von Aspergillus versicolor und Aspergillus nidulans,Patulin von Aspergillus clavatum und anderen Schimmelpilzen ausgeschieden. Aspergillus fumigatus ist der wichtigste Erreger der Aspergillose und kann auch Allergien auslösen. Andererseits werden Aspergillus-Arten seit Jahrtausenden zur Herstellung von Nahrungsmitteln genutzt und haben heute auch große Bedeutung in der Biotechnologie: Bei der Produktion von Sake in Japan und vieler orientalischer Nahrungsmittel (z. B. Sojasauce, Miso) dient Aspergillus oryzae zum Aufschluß von Stärke und Proteinen. Amylasen (Takadiastase, Takaamylase), Pektinasen, Proteinasen und andere Enzyme werden auch aus den Pilzen gewonnen und bei der Traubensaftherstellung (Trübungsbeseitigung) sowie in der Leder- und Textilindustrie eingesetzt (Aspergillus oryzae, Aspergillus niger). Viele Säuren lassen sich biotechnologisch mit Aspergillus gewinnen, z. B. Citronensäure, Gluconsäure(Aspergillus niger) und Itaconsäure(Aspergillus itaconicus). Aspergillus-Arten werden bei der Biotransformation in der Carotinoid- und Steroidsynthese eingesetzt; auch proteinhaltige Biomasse aus polymeren Kohlenhydraten (Stärke, Cellulose, Chitin) läßt sich mit Aspergillus gewinnen. Es gibt ferner Antibiotikaproduzenten, z. B. Aspergillus fumigatus (Fumigatin) und Aspergillus flavus (Aspergillsäure). Aspergillus wird auch als Modellorganismus (Modellorganismen) für genetische Untersuchungen und in der Gentechnologie genutzt. Bodenorganismen, Cordycepin, Giftpilze, Gliotoxin, Heterokaryose, Konservierung, Selbsterhitzung.
G.S.
Lit.:Brakhage, A., Jahn, B., Schmidt, A. (ed.): in Contributions to Microbiology. Vol. 2: Aspergillus fumigatus. Biology, Clinical Aspects and Molecular Approaches to Pathogenicity. Basel 1998.

Wenn Sie inhaltliche Anmerkungen zu diesem Artikel haben, können Sie die Redaktion per E-Mail informieren. Wir lesen Ihre Zuschrift, bitten jedoch um Verständnis, dass wir nicht jede beantworten können.